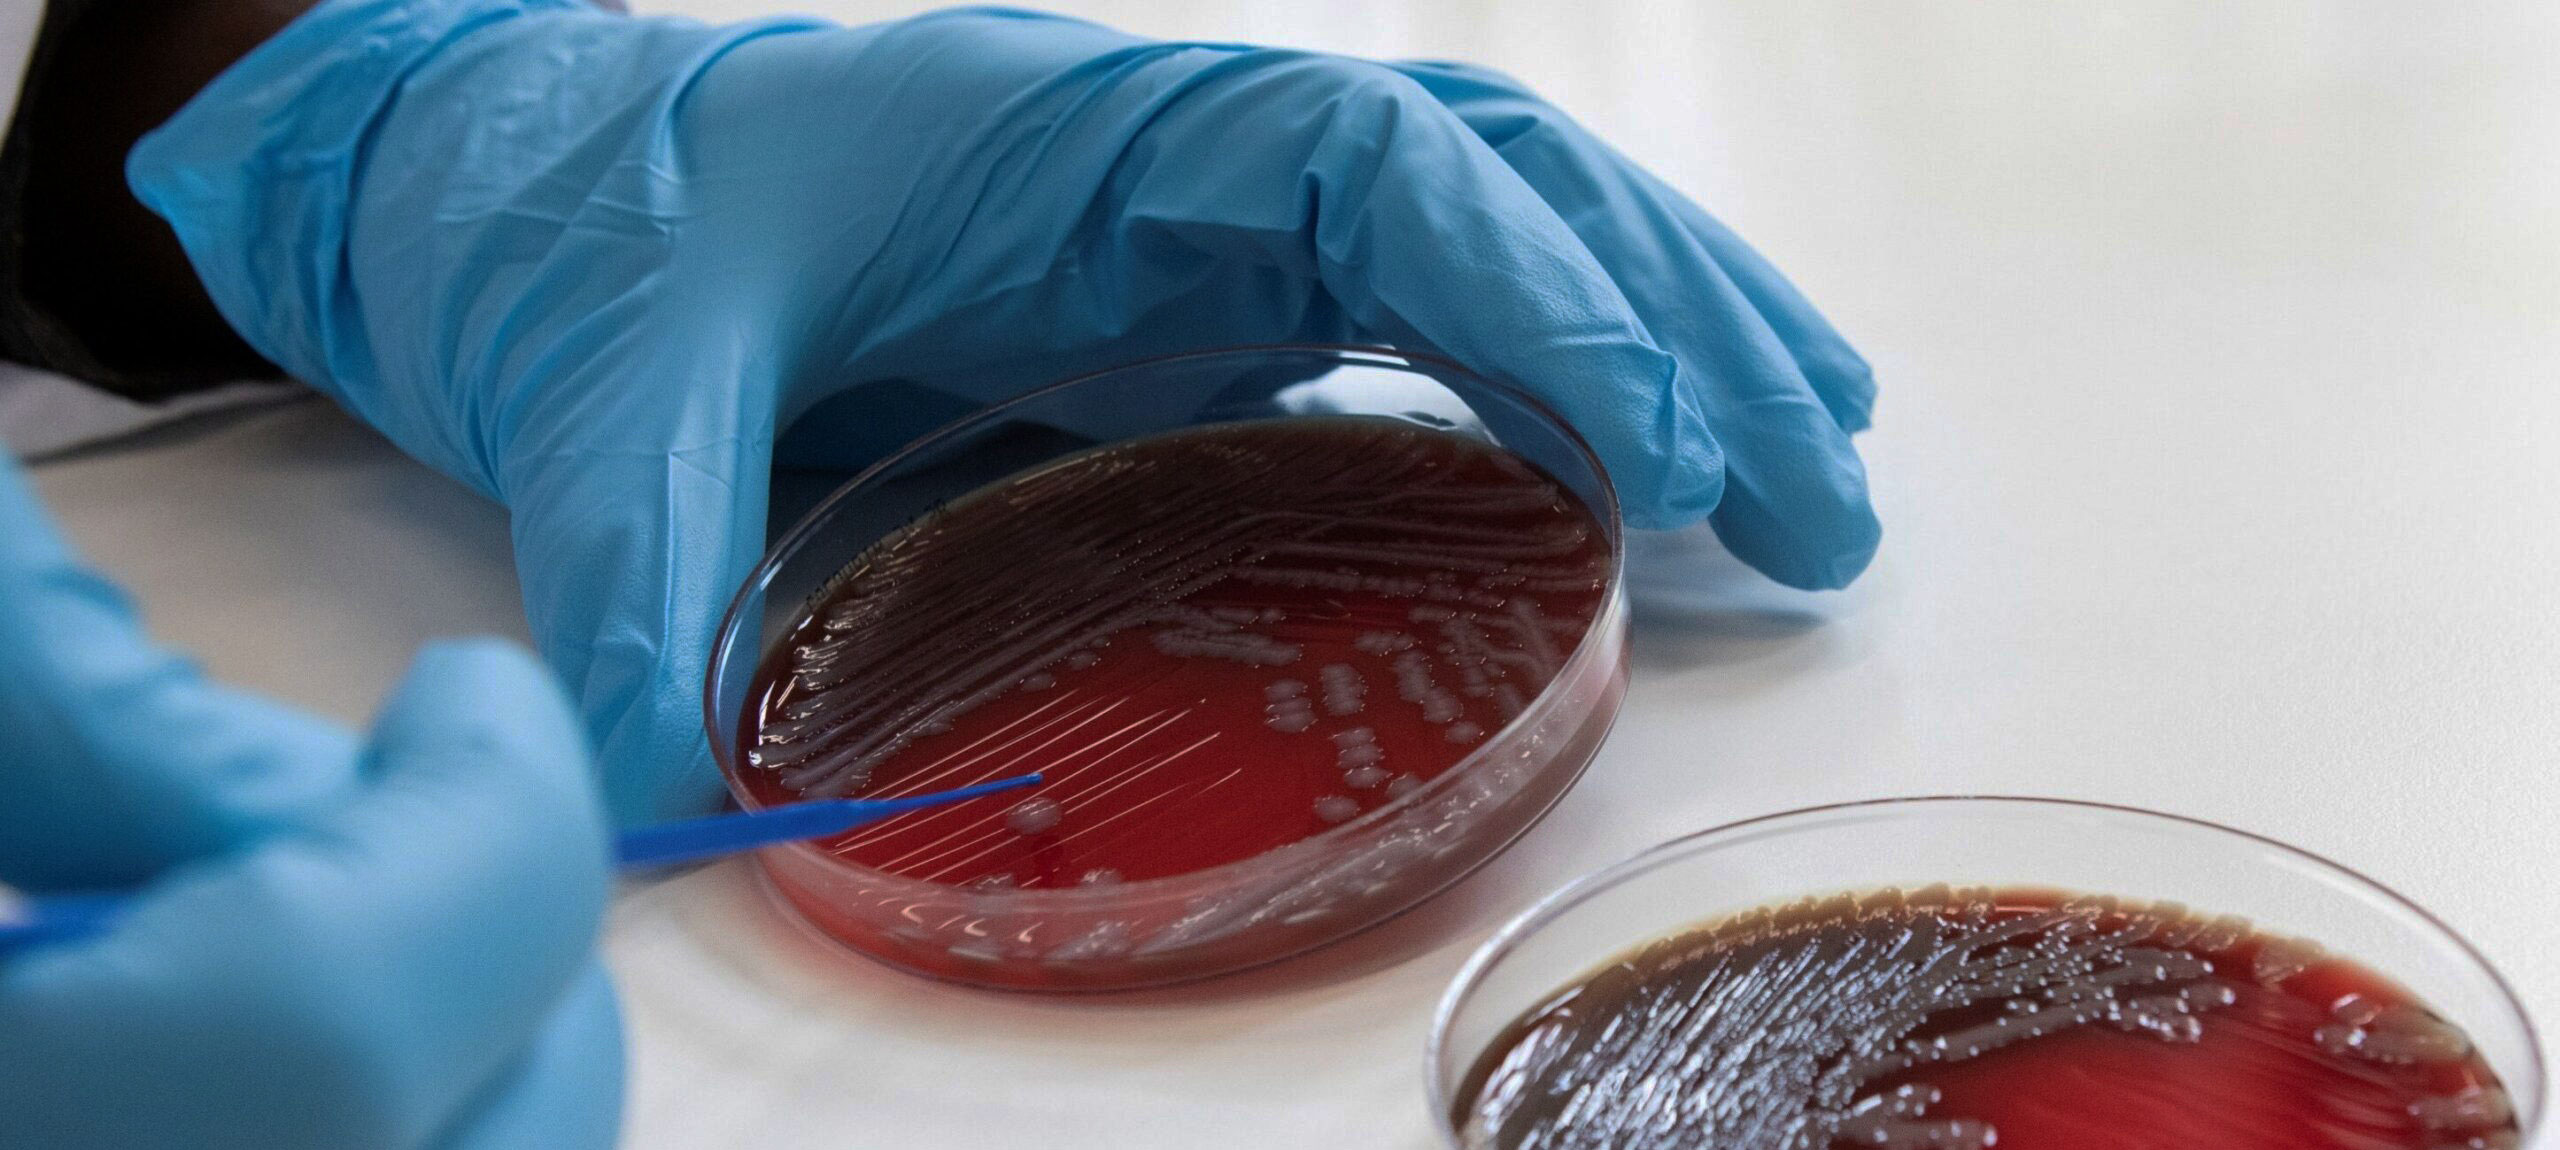

Unlocking
technical resources
in microbiology
We are improving global access to technical resources to maximize the effective use of existing microbiological diagnostics.
The Global Alliance for Microbiology (GAM) is a not-for-profit collaboration formed and supported by multiple NGOs, academic institutions, technical partners, and professionals. We are committed to a collaborative approach for reviewing, endorsing, and making existing technical resources for diagnostic microbiology available open-access (on- and off-line).
GAM was initiated in 2024 by like-minded scientists to improve access to qualitative, peer-reviewed microbiology procedures. Despite long-standing recognition of the need for open-access, standardized laboratory tools, no global, peer-reviewed repository exists to curate, endorse, and disseminate such materials for routine use in LMIC laboratories. GAM strives to change this!
In the coming months, this website will be filled with reviewed and GAM-endorsed laboratory procedures, that can be adapted to your settings and needs.
Vision
To strengthen microbiology laboratory practice in LMIC, to improve prevention, diagnosis, management and surveillance of major infectious diseases.
Mission
To provide a collaborative platform for the technical review, endorsement, and dissemination of practical existing tools for building and sustaining high-quality microbiology testing, in the areas of:
- Diagnostic microbiology, initially with a primary focus on bacteriological and mycological detection, identification and antimicrobial susceptibility testing (AST)
- Specimen collection, test selection, test interpretation, reporting, and related laboratory information systems
- Quality Management Systems for Microbiology testing
- Human resource capacity development and competency assessment
- Identification and promotion of effective laboratory strengthening initiatives
- Local production of quality culture media and reagents
- Post analytical procedures including result reporting, clinician liaison, AMR surveillance and laboratory key performance indicators for microbiology
Governance
GAM is led by an inaugural steering committee, consisting of six member currently. Two more members will be attracted still in 2026. The Steering Committee will be yearly renewed, two members will be replaced, from 2027 on, at the yearly GAM member meeting at ESCMID Global.
